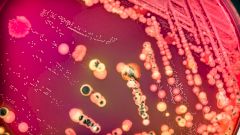
Как бактерии могут влиять на ваш вес

Как бактерии могут влиять на ваш вес
Ваше тело содержит триллионы бактерий. Большинство этих бактерий расположены в вашем кишечнике.
Кто хозяин в организме человека?
Ваш организм содержит больше бактериальных клеток, нежели человеческих клеток. Эти бактерии в основном находятся в вашем кишечнике и выполняют важные задачи для поддержания вашего здоровья.
Уровень жира
Бактерии кишечника играют важную роль в поддержании вашего здоровья. Они могут влиять на переваривание еды и работу иммунной системы. Согласно исследованиям, ученых из Королевского колледжа Лондона, кишечные бактерии могут влиять на уровень содержания жира в организме.
Ты — то, что ты ешь
Ваши кишечные бактерии могут влиять и на ваш вес, воздействуя на то, как переваривается еда в вашем организме. Клетчатка и цельные зерна перевариваются определенными видами кишечных бактерий, что может помочь снижению веса.
У людей, чей рацион состоит в основном из еды, богатой углеводами и клетчаткой, больше бактерий — Prevotella. А у людей, кто регулярно питается животным белком и жиром преобладают бактерии — Bacteroidetes.

Они влияют на функцию кишечника
Определенные типы кишечных бактерий важны для регуляции проницаемости стенок кишечника и защиты организма от проникновения нежелательных бактерий, синдрома воспаленного кишечника. Такими полезными бактериями являются бифидобактерии и аккермансия.
За чувство сытости отвечают кишечные бактерии
Ваши кишечные бактерии могут производить химические вещества, которые позволяют вам ощущать сытость. Воздействуя на ваш аппетит, бактерии могут повлиять и на вес. Вот гормоны, которые влияют на ваш аппетит: лептин, грелин, пептид YY (PYY).
Лучшие продукты для микрофлоры кишечника
- Цельные зерна, злаки
- Фрукты и овощи
- Орехи и семена
- Продукты, богатые полифенолом (какао, зеленый чай)
- Ферментированные продукты (кефир, йогурт, квашеная капуста)
- Пробиотики
Не стоит употреблять в избытке продукты, которые содержат сахар, искусственные подсластители, транс-жиры. Эти продукты могут нанести серьезный вред вашим бактериям.
ЧИТАЙТЕ ТАКЖЕ: Человек — ходячая суперколония микробов